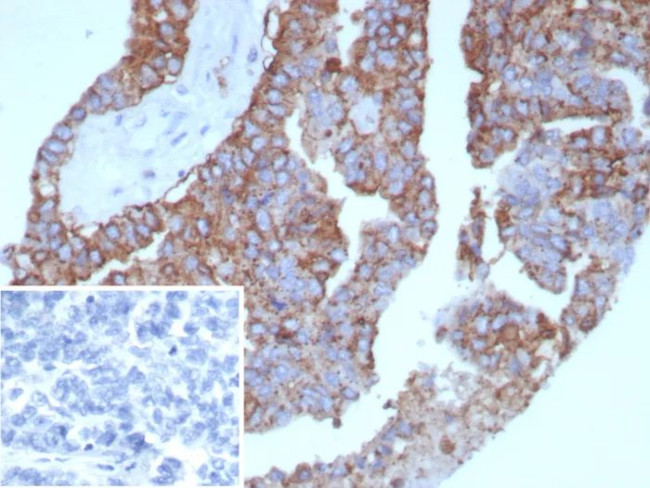
Pan-HLA-II (DP, DQ, DR) Antibody in Immunohistochemistry (Paraffin) (IHC (P))

Search
NeoBiotechnologies
Pan-HLA-II (DP, DQ, DR) Recombinant Mouse Monoclonal Antibody (rHLA-Pan/8847)
{{$productOrderCtrl.translations['antibody.pdp.commerceCard.promotion.promotions']}}
{{$productOrderCtrl.translations['antibody.pdp.commerceCard.promotion.viewpromo']}}
{{$productOrderCtrl.translations['antibody.pdp.commerceCard.promotion.promocode']}}: {{promo.promoCode}} {{promo.promoTitle}} {{promo.promoDescription}}. {{$productOrderCtrl.translations['antibody.pdp.commerceCard.promotion.learnmore']}}
产品信息
MSM6-8847-P1
种属反应
宿主/亚型
Expression System
分类
类型
克隆号
抗原
偶联物
形式
浓度
规格
纯化类型
保存液
内含物
保存条件
运输条件
产品详细信息
Positive Control:Raji cells. Human tonsil or lymph node.
Cellular Location: Cell surface
靶标信息
MHC class II molecules are transmembrane glycoproteins composed of an alpha chain (36 kDa) and a beta chain (27 kDa). They are expressed primarily on antigen presenting cells such as B lymphocytes, monocytes, macrophages, thymic epithelial cells and activated T lymphocytes. Three loci, DR, DQ and DP, encode the major expressed products of the human class II region. The human MHC class II molecules bind intracellularly processed peptides and present them to T-helper cells. They therefore have a critical role in the initiation of the immune response.
HLA and MHC antibodies play a significant role in Immunopeptidomics, facilitating the identification and characterization of neoantigens through high-performance liquid chromatography coupled to tandem Mass Spectrometry.
仅用于科研。不用于诊断过程。未经明确授权不得转售。
篇参考文献 (0)
生物信息学
蛋白别名: cell surface glycoprotein; integral membrane protein; class II HLA histocompatibility antigen; DP beta 1 domain protein; DR beta-5; DR2-beta-2; DR7 beta-chain glycoprotein; DRB1; DRB52; DRw53 beta-chain glycoprotein; Dw2; ERLA-005; FLJ75017; FLJ76359; histocompatibility antigen HLA-DR alpha; HLA class II histocompatibility antigen, DP beta 1 chain; HLA class II histocompatibility antigen, DP(W4) beta chain; HLA class II histocompatibility antigen, DQ beta 1 chain; HLA class II histocompatibility antigen, DR alpha chain; HLA class II histocompatibility antigen, DR beta 3 chain; HLA class II histocompatibility antigen, DR beta 4 chain; HLA class II histocompatibility antigen, DR beta 5 chain; HLA class II histocompatibility antigen, DR-1 beta chain; HLA class II histocompatibility antigen, DR-5 beta chain; HLA class II histocompatibility antigen, DRB1 beta chain; HLA DP4 beta-chain; HLA DRB3; HLA-D; HLA-DP histocompatibility type, beta-1 subunit; HLA-DQ; HLA-DQ-beta-1 cell surface glycoprotein; HLA-DQB1; HLA-DR; HLA-DR alpha-chain; hla-dr antigen alpha chain; hla-dr antigen beta chain; hla-dr antigen heavy chain; HLA-DR-alpha chain precursor; HLA-DR-beta chain; HLA-DR11-14N allele; HLA-DRA; HLA-DRB1; human leucocyte antigen; human leucocyte antigen DRB1; human leucocyte antigen DRB3; Human leukocyte antigen DRB1; leukocyte antigen; light chain; lymphocyte antigen DRB1; major histocompatibility complex, class II, DRB3; MHC Class 2; MHC class II; MHC class II antigen; MHC class II antigen DPB1; MHC class II antigen DQB1; MHC class II antigen DR beta 3 chain; MHC class II antigen DRA; MHC class II antigen DRB3; MHC class II antigen DRB4; MHC class II antigen DRB5; MHC class II antigen HLA-DQ-beta-1; MHC class II DQ beta chain; MHC class II DQ-beta protein precursor; MHC class II DQ3.1ER protein; MHC class II DR beta chain; MHC class II HLA-DP-beta-1; MHC class II HLA-DQ beta glycoprotein; MHC class II HLA-DR beta 1 chain; MHC class II HLA-DR beta 3 chain; MHC class II HLA-DR4 protein; MHC class II HLA-DR4/w53 protein; MHC class II protein; MHC DQ beta protein precursor; MHC DQ-beta chain; MHC DQw1-beta surface glycoprotein; MHC DR beta protein precursor; MHC DR-beta; MHC DR7-beta-1 chain; MHC DR7-beta-2 chain; MHC HLA DPB1; MHC HLA DR5 cell surface glycoprotein beta chain precursor; MHC HLA-D; MHC HLA-DC-beta chain precursor; MHC HLA-DPw4b-beta chain precursor; MHC HLA-DQ-beta cell surface glycoprotein; MHC HLA-DQ-beta chain precursor old gene name 'HLA-DQB'; MHC HLA-DQ-beta precursor; MHC HLA-DQB1-beta protein; MHC HLA-DR-beta chain; MHC HLA-DR-beta chain precursor; MHC HLA-DR-beta chain precursor old gene name 'HLA-DRA1'; MHC HLA-DR-beta surface glycoprotein; MHC HLA-DR-beta-1 chain; MHC HLA-DR-beta-1 precursor; MHC HLA-DR-beta-2 precursor; MHC HLA-DR1-beta; MHC HLA-DR2 (non-Dw2/non-Dw12)b glycoprotein beta-chain; MHC HLA-DR2(Dw12)a glycoprotein beta-chain; MHC HLA-DR2(Dw12)b glycoprotein beta-chain; MHC HLA-DR2(Dw2)a glycoprotein beta-chain; MHC HLA-DR2(Dw2)b glycoprotein beta-chain; MHC HLA-DR2(non-Dw2/non-Dw12)a glycoprotein beta-chain; MHC HLA-DRQ-beta chain; MHC HLA-DRw10-beta-2 protein precursor; MHC HLA-SB-beta chain I; MHC II HLA; SB-beta chain; unnamed protein product; XXbac-BPG161M6.1
基因别名: CELIAC1; DPB1; DR4; DRB1; DRB3; DRB4; DRB5; HLA-DP; HLA-DP1B; HLA-DPB; HLA-DPB1; HLA-DQB; HLA-DQB1; HLA-DR1B; HLA-DR3B; HLA-DR4B; HLA-DRA; HLA-DRA1; HLA-DRB; HLA-DRB1; HLA-DRB3; HLA-DRB3*; HLA-DRB4; HLA-DRB4*; HLA-DRB5; HLA-DRB5*; IDDM1; SS1
UniProt ID: (Human) P79608, (Human) P01920, (Human) P01903, (Human) P01911, (Human) P79483, (Human) P13762, (Human) Q30154
Entrez Gene ID: (Human) 3115, (Human) 3119, (Human) 3122, (Human) 3123, (Human) 3125, (Human) 3126, (Human) 3127